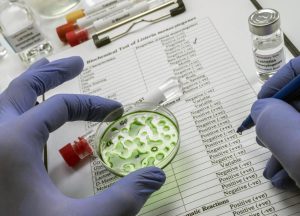

Depleted Bruins fall to Rangers, 6-2
With all the absences from their lineup, the Bruins needed to play about a perfect game to come out on top of the New York Rangers in the annual Black Friday matchup at the Garden.
And the B’s were far from perfect.
After falling behind 4-0 in the first two periods, the B’s made a spirited comeback attempt in the third period to cut the deficit to two goals but they just didn’t have enough firepower to climb out of that deep of a hole. Down a pair late, oach Marco Sturm pulled Joonas Korpisalo for an extra skater with just under four minutes left and Alexis LaFreniere sealed it with an empty netter. Vladislav Gavrikov added a garbage time goal and the Rangers skated away with a 6-2 win.
The Bruins were already beset with injuries with Charlie McAvoy and Viktor Arvidsson out, but they also found out Friday morning that both David Pastrnak and Pavel Zacha were unavailable due to unspecified maladies.
That forced Casey Mittelstadt, out since November 6, into the lineup without the benefit of a team practice and Georgii Merkulov was called up from Providence. Meanwhile, with Matej Blumel shifted to LTIR with a lower body injury he suffered on Wednesday, Riley Tufte was re-inserted into the lineup.
The result in the first period was a predictably disjointed look. The Rangers took a 2-0 lead as the B’s played much of the first 20 minutes either in their own zone or chasing a neutral zone turnover.
That’s how the Blueshirts got on the board first just 3:28 into the game. Jonathan Aspirot stepped up for a loose puck at the red line but Will Cuylle beat him to it, tipping it past him to create a 2-on-1 with Artemi Panarin, who beat Joonas Korpisalo with a wrist shot form the right circle.
The B’s briefly thought they’d tied it up on a good shift from the fourth line but it was clear they Tufte had shoved Igor Shesterkin, along with the puck, into the net and it was correctly washed out by the ref.
The Rangers took a 2-0 lead on an odd play. From the right boards, Vincent Trocheck threw a puck intended for the slot but it went all the way through to bounce off the left boards. That set it up on a tee for wide open left defenseman Carson Soucy, who stepped into a slapper and blew it past Korpisalo.
The B’s had chances to cut the deficit. On a late first period power play, Elias Lindholm pushed a puck in their air to Morgan Geekie at the side of the net but Geekie whiffed on it on the aerial biscuit.
Then they had a couple of excellent chances early in the second. First, Shesterkin made a great post-to-post save on an Alex Steeves bid on a 2-on-1 with Geekie. And a little later, Geekie had an open net at which to shoot but Steeves’ feed was just off target.
The Rangers withstood the B’s surge and then took advantage of the B’s pencant for penalties. The B’s were in the process of killing off a Marat Khusnutdinov high-stick when disaster struck. With six seconds left on the Khusnutdinov penalty, Hampus Lindholm took a double minor for high-sticking Jonny Brodzinski.
Just as Khusnutdinov was about to get out of the box, Mika Zibanejad scored from below the left circle.
It was officially a 5-on-4 goal so one of the Hampus Lindholm minors was wiped out, but it didn’t help the B’s any. Zibanejad scored his second of second in 45 seconds at 15:07 and the Blueshirts were well on their way, up 4–0.
The B’s would not suffer their first shutout of the season, however. Mittelstadt broke it up at 4:07 of the third when, from the top of the crease, he finally got his stick on a loose puck and scored his fifth of the season.
With the B’s buzzing, Ranger coach Mike Sullivan called his timeout to settled things down, but it didn’t quite work.
Geekie scored his 18th of the season at 5:49 when he tipped Henri Jokiharju’s shot past Shesterkin and the B’s had some life.
That, however, was as close as they would get.